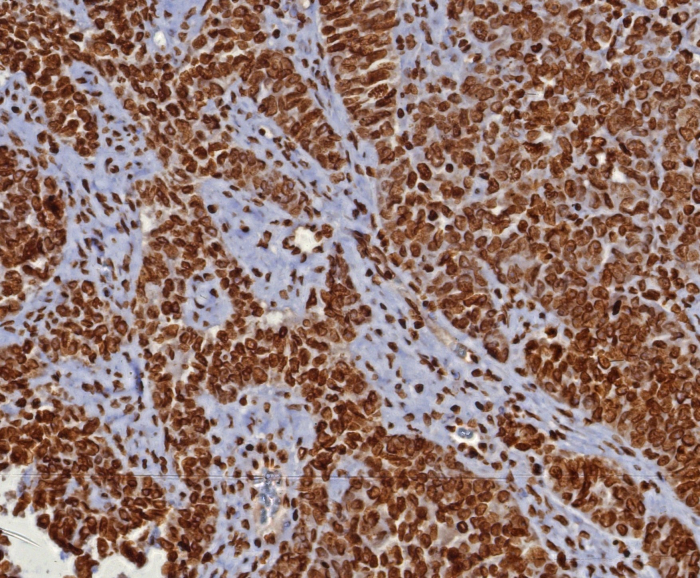
dsDNA Antibody (DSD/8204R)

dsDNA Antibody (DSD/8204R)
Novus Biologicals, part of Bio-Techne | Catalog # NBP3-20582
Recombinant Monoclonal Antibody


Conjugate
Catalog #
Forumulation
Catalog #
Key Product Details
Species Reactivity
Human
Applications
Immunohistochemistry-Paraffin
Label
Unconjugated
Antibody Source
Recombinant Monoclonal Rabbit IgG Kappa Clone # DSD/8204R
Concentration
0.2 mg/ml
Product Specifications
Immunogen
Nuclei of Burkitt's cells
Localization
Nucleus.
Specificity
This monoclonal antibody recognizes the double stranded DNA in human cells It can be used to stain the nuclei in cell or tissue preparations and can be used as a nuclear marker in human cells This monoclonal antibody produces a homogeneous staining pattern in the nucleus of normal and malignant cells
Clonality
Monoclonal
Host
Rabbit
Isotype
IgG Kappa
Description
Positive Controls: Raji, Jurkat or HeLa cells. Human tonsil or colon.
Antibody with azide - store at 2 to 8C. Antibody without azide - store at -20 to -80C. Non-hazardous. No MSDS required.
Antibody with azide - store at 2 to 8C. Antibody without azide - store at -20 to -80C. Non-hazardous. No MSDS required.
Scientific Data Images for dsDNA Antibody (DSD/8204R)
dsDNA Antibody (DSD/8204R)
Formalin-fixed, paraffin-embedded human placenta stained with dsDNA antibody (DSD/8204R). HIER: Tris/EDTA, pH9.0, 45min. Secondary: HRP-polymer, 30min. DAB, 5min.dsDNA Antibody (DSD/8204R)
Formalin-fixed, paraffin-embedded human ovarian cancer (serous) stained with dsDNA antibody (DSD/8204R). HIER: Tris/EDTA, pH9.0, 45min. Secondary: HRP-polymer, 30min. DAB, 5min.Applications for dsDNA Antibody (DSD/8204R)
Application
Recommended Usage
Immunohistochemistry-Paraffin
1-2 ug/ml
Application Notes
Immunohistochemistry (Formalin-fixed): 1-2ug/ml for 30 minutes. at RT. Staining of formalin-fixed tissues requires heating tissue sections in 10mM Tris with 1mM EDTA, pH 9.0, for 45 min at 95C followed by cooling at RT for 20 minutes.
Optimal dilution for a specific application should be determined.
Optimal dilution for a specific application should be determined.
Formulation, Preparation, and Storage
Purification
Protein A purified
Formulation
10mM PBS with 0.05% BSA
Preservative
0.05% Sodium Azide
Concentration
0.2 mg/ml
Shipping
The product is shipped with polar packs. Upon receipt, store it immediately at the temperature recommended below.
Stability & Storage
Store at 4C. Do not freeze.
Background: dsDNA
Alternate Names
Double stranded DNA
Additional dsDNA Products
Product Documents for dsDNA Antibody (DSD/8204R)
Product Specific Notices for dsDNA Antibody (DSD/8204R)
This product is for research use only and is not approved for use in humans or in clinical diagnosis. Primary Antibodies are guaranteed for 1 year from date of receipt.
Loading...
Loading...
Loading...
Loading...